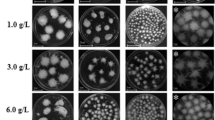

Abstract
β-mannanase was produced mainly by Aspergillus species and can degrade the β-1,4-mannose linkages of galactomannans. This study was undertaken to enhance mannanase production using talcum and aluminum oxide as the microparticles, which control cell morphology of recombinant Aspergillus sojae in glucose and carob extract medium. Both microparticles improved fungal growth in glucose and carob pod extract medium. Aluminum oxide (1 g/L) was the best agent for glucose medium which resulted in 514.0 U/ml. However, the highest mannanase activity was found as 568.7 U/ml with 5 g/L of talcum in carob extract medium. Increase in microparticle concentration resulted in decreasing the pellet size diameter. Furthermore, more than 10 g/L of talcum addition changed the filamentous fungi growth type from pellet to pellet/mycelium mixture. Results showed that right type and concentration of microparticle in fermentation media improved the mannanase activity and production rate by controlling the growth morphology.
Similar content being viewed by others
Avoid common mistakes on your manuscript.
Introduction
Enzymes, protein-based organic materials, are catalyzer of the specific reactions in animal and plant cells. They could be extracted by different methods and used in vivo or in vitro under available conditions (stable pH, temperature, water activity etc.). However, getting enough enzyme extract from animal or plant sources is not economical and practical approach for the enzyme industry. Therefore, enzyme industry uses microorganisms or genetically modified microorganisms to produce specific enzymes or enzyme mixtures. For example, rennin, amylases, pectinases, hemicellulases are the most commonly produced enzymes in the world. β-mannanase is another industrial enzyme, which degrades simultaneously the β-1,4-mannose linkages of galactomannans and produces mannose oligosaccharides [1, 2] and commonly used in detergent formulations, pharmaceutical applications, paper and pulp production, animal feeds, instant coffee production, manno-oligosaccharides production etc. [3, 4].
β-mannanase is mainly produced by filamentous fungi including different Aspergillus species [3], and also Bacillus subtilis [5, 6], Bacillus licheniformis [7], Escherichia coli [8], Paenibacillus cookie [9], Pantoea agglomerans [10], Pichia pastoris [11–13], and Sclerotium rolfsii [14]. However, most of them are very efficient for industrial production. Therefore, there are some efforts to develop genetically modified strains to improve β-mannanase [3].
Different fermentation strategies, techniques and fermentation conditions can affect the fermentation performance. In addition, the purified carbon sources (glucose, lactose, sucrose etc.) are preferred for fermentations. However, the researchers have always been investigating new carbon sources. For example, molasses [15] and apple pomace [9] were used for mannanase production as the carbon source. Carob pod was also reported to be carbon source due to its high sugar content (34–42 % sucrose, 10–12 % fructose and 7–10 % glucose) for fermentation [16, 17].
On the other hand, researchers are continuously investigating new approaches to improve production yield. Nowadays, one of the new approaches is microparticle addition to fermentation medium to control hyphae development and undesirable changes during biotechnological processes, because microparticle addition enables more stable hyphae development. Consequently, the substrate utilization, agitation and enzyme production could be more stable, higher and repeatable. Recently, different microparticles such as talcum (magnesium silicate), aluminum oxide, and titanium oxide have been used to enhance the yield values of production by researchers. Caldariomyces fumago was used to produce chloroperoxidase (CPO) with and without different microparticles [aluminum oxide (Al2O3) and talcum (hydrous magnesium silicate, Mg3O·Si4O2·H2O)]. It was reported that the particles of ≤42 µm had more positive effect than the particles of ~500 µm in diameter on CPO production, and CPO activity in the culture supernatant was 1000 U/ml after 10–12 days [18]. Aspergillus niger was performed to produce fructofuranosidase and glucoamylase enzyme mix with different concentrations (0–50 g/L) of titanium silicon oxide microparticle (TiSiO4; 8 μm). The best concentration of TiSiO4 was 25 g/L and the pellet diameter changed from 1.7 to 0.3 μm. The fructofuranosidase and glucoamylase productions were significantly improved by 3.7- and 9.5-fold times, respectively [19]. Driouch et al. [20] was also reported that free mycelium was formed with increasing the concentration of microparticles (talcum or aluminum oxide), however it should be used to more aluminum oxide than talcum for obtaining free mycelium form [19].
Aspergillus ficuum phytase production was also studied with talcum and aluminum oxide in shake flask fermentation [21]. Addition of 15 g/L of aluminum oxide and talcum was decreased (pellet diameter) from 800 μm to 500 and 200 μm, respectively. The phytase activity was increased from 1.02 U/ml (control) to 2.01 U/ml with 15 g/L of talcum and 2.93 U/ml with 15 g/L of aluminum oxide in shake flask fermentation. It was also determined that the phytase activity reached to 6.49 U/ml at 96 h (the control was 3.45 U/ml at 120 h) in bench-top bioreactors [21]. Fed-batch and continuous fermentations strategies were studied to produce phytase and fungal pellet radius decreased from 500 to 100 μm with 15 g/L of talcum in the bioreactors [22]. Talcum addition increased productivity and optimum dilution rate values in the continuous fermentations from 0.293 to 0.621 U/ml/h and from 0.09 to 0.1 1/h, respectively [22]. The other research about the lactic acid production by Rhizopus oryzae was studied to improve the fermentation results with aluminum oxide or talcum [23]. The shake flask fermentation was showed that 15 g/L aluminum oxide or 10 g/L talcum addition increased the lactic acid concentration from 6.02 to 13.88 and 24.01 g/L, respectively. They also studied the bioreactor fermentations. Result showed that the highest lactic acid concentration for 10 g/L talcum was 75.1 g/L with 126 g/L of glucose, pH 6.22 and 387 rpm [23].
The hyphae development during fungal growth is hard to control in medium, because the spores of fungal cell want to inosculate another spore. The hyphae stack was blocked the extracellular enzyme to let out of the cell. Therefore, researchers have started to look for new fermentation techniques to control fungal cell growth and enhance the productivity. In this research, two microparticles (talcum and aluminum oxide) have been used with different concentrations to enhance β-mannanase activity and to control fungal morphology in pure glucose and carob pod extract medium using genetically modified Aspergillus sojae.
Materials and methods
Microorganism
Recombinant Aspergillus sojae transformant 1 (AsT1) was obtained from Prof. Dr. Z. B. OGEL laboratory at Middle East Technical University, Ankara, Turkey [24]. It was pre-cultured on Potato Dextrose Agar (PDA) at 30 °C for 4–5 days, and stored at 4 °C [15]. For inoculum preparation, surface of each plate was rinsed with 10–20 ml of sterile solution of %0.05 Tween-80 and %0.85 NaCl. Then, the obtained spore suspension was stored at 4 °C and used as the inoculation (~107 spores/ml). The stock spore solution was prepared monthly basis.
Glucose and carob pod extract medium
Shake flask fermentations were performed in glucose medium (40 g/L of glucose, 4 g/L of yeast extract, 0.5 g/L of MgSO4·7H2O, and 1 g/L of K2HPO4) and carob pod extract medium (4 ºBx carob pod extract was supplemented with 4 g/L of yeast extract, 0.5 g/L of MgSO4·7H2O, and 1 g/L of K2HPO4). The carob pod generally has 91–92 % total dry weight content and 62–67 % total soluble solids, which primarily consist of sucrose (34–42 %), glucose (7–10 %), fructose (10–12 %) and also incorporate minor amounts of amino acids, minerals and phenolic compounds [17]. The carob pod extract was prepared by using chopped carob pods without seeds (provided by Yenigün Corp., Antalya, Turkey) at 80 °C for 2 h in a deionized water with 1:4 carob pod:water ratio [16]. The carob pod extract was adjusted to 4 ºBx and enriched with the nitrogen source and mineral salts as described above.
Shake flask fermentation
All shake flask fermentations were performed duplicated with 100 ml fermentation medium which were supplemented with 0, 1, 3, 5, 10, 15, 20, and 25 g/L of aluminum oxide (Al2O3, Sigma 11,037, powder) (suspended in 100 mM citrate buffer-pH 6.5) or talcum (3MgO·4SiO2·H2O, Sigma 243,604, hydrous magnesium silicate, powder, 10 µm particle size) (suspended in 50 mM Na-acetate buffer-pH 6.5). For the fermentation, 10 ml microparticle suspension and 90 ml of fermentation medium were autoclaved separately, and mixed aseptically after cooling down to the room temperature. Then, fermentation medium including microparticles was inoculated with the prepared spore suspension (5 %). Fermentation was performed at 30 °C and 200 rpm for 10 days. Samples were taken daily and analyzed for mannanase activity, sugar concentration and pellet size.
β-Mannanase analysis
Enzyme activity was measured by taking 0.2 ml of cell free fermentation broth sample and mixing with 1.8 ml 0.05 % w/v locust bean gum solution (prepared in 0.1 M Na-citrate buffer; pH 6). After the samples were incubated at 50 °C for 5 min, 3 ml DNS (3′,5′-dinitrosalicylic acid) solution were added the sample tubes immediately, and the mixture was heated at 90 °C for 15 min to accelerate the reaction for the color change and was cooled. The absorbance values were determined at 540 nm by using a spectrophotometer (Thermo Scientific Evolution 201, Waltham, MA, USA) [25]. Absorbance values were converted to mannanase activity using the generated standard curve equations as shown in Eqs. 1 and 2.
where C mannose = mannose concentration (µmole/ml)
where R v = Volume of total solution in test tube/Volume of enzyme solution, DF = Dilution factor, t = duration of the reaction in minutes.
Residual sugar analysis
Sugar analyses were performed by DNS method [26]. Absorbance values were converted to residual sugar concentration using the standard curve equation (Eq. 3)
Pellet size determination
Fungal morphology and pellet radius was analyzed by a stereo-microscope (Stemi 2000-C, Zeiss, Germany) with an AxioCamERc5 camera (Stemi 2000-C, Zeiss, Göttingen, Germany). Biomass samples were washed with deionized water to remove medium and microparticles from the pellets. Then, biomass samples were analyzed and pellets average size was determined [19]. The image analyses were performed with the ImageJ program. First of all, the pellets of the sample picture were contrasted to be black. And then, the program was calculated the size of each pellets.
Statistical analysis
All fermentations and measurement were carried out duplicate. Data were subjected to analysis of variance using the General Linear Models procedure of the Statistical Analyses System software (Version 7, SAS Institute Inc., Cary, NC). Differences among the mean values of the various treatments were calculated and the significance was defined at p < 0.05.
Results and discussion
In this study, different carbon sources (glucose and carob pod extract) and microparticles (aluminum oxide and talcum) used for β-mannanase production.
β-Mannanase production with microparticles in glucose medium
Aluminum oxide
Shake flask fermentations with glucose medium showed that β-mannanase activity and pellet size diameter varied as the concentration of the aluminum oxide changed (Fig. 1a). For example, addition of 1 g/L aluminum oxide increased the enzyme activity to 514.0 U/ml while the control was 199.3 U/ml. Addition of aluminum oxide more than 1 g/L resulted in decreased β-mannanase activities. Addition of 3 or 25 g/L of aluminum oxide addition decreased β-mannanase activity to 177.8 and 163.7 U/ml, respectively. These results showed that the amount of microparticle was an important parameter to enhance the mannanase activity. So for glucose medium the best aluminum oxide concentration was determined to be 1 g/L.
The highest consumption rate was 7.0 g/L/day without aluminum oxide addition (control), but the highest production rate was 57.0 U/ml/day with 1 g/L of aluminum oxide addition. Mannanase activity results except 1 and 20 g/L of aluminum oxide were lower than control but all of the production rate values were higher than control. It was carried out that the addition of aluminum oxide improved the production rate results for all concentrations (Table 1). It was shown that the correct amount of aluminum oxide addition also reduced the sugar consumption and improved β-mannanase production. However, higher aluminum oxide additions increased the sugar consumption rate and caused the lower β-mannanase activity.
Talcum
The use of talcum as the microparticles in glucose medium was also performed to improve mannanase production rate, mannanase activity, and results are given in Fig. 1b. The β-mannanase activity for control fermentation was 199.3 U/ml, but the highest activity for different talcum concentration was 85.1 U/ml for 1 g/L. Talcum usage in glucose medium for shake flask fermentation was not given higher results than control. It could be about the fungal morphology type. Because, the microorganism growth type was small pellets or small pellets + filamentous for all of talcum concentrations except 1 g/L. So it was carried out that the microorganism growth type was important for mannanase activity results (Table 1).
Talcum addition was improved the sugar consumption rates from 7.0 g/L/day (control) to 11.9 g/L/day (25 g/L of talcum) but did not improve the mannanase activity, which yielded the lowest production rate (9.2 U/ml/day) when the talcum concentration was 25 g/L in medium. Addition of more than 10 g/L of aluminum oxide was also improved the sugar consumption rate and it was resulted in decreased β-mannanase activity. The addition of higher concentration of talcum was changed the microorganism growth type from pellets to small pellets + filamentous, and it was resulted in higher cell density but the lower mannanase activity (Table 1).
β-Mannanase production with microparticles in carob pod extract medium
Aluminum oxide
Different concentrations of the aluminum oxide (0, 1, 3, 5, 10, 15, 20, and 25 g/L) were added to carob pod extract medium. The β-mannanase activity and pellet radius changes are given in Fig. 2a. The results showed that 1 and 15 g/L of aluminum oxide concentration increased the β-mannanase activity from 310.5 U/ml (control) to 343.6 U/ml and 335.6 U/ml, respectively. There was no difference between control and 1, 15, and 25 g/L of aluminum oxide sugar consumption results but all of the production rate values were lower than the control fermentation (36.0 U/ml/day). It was also observed that the concentrations higher than 15 g/L of aluminum oxide decreased the β-mannanase activity. Therefore, results showed that optimal amount of the aluminum oxide for flask fermentation was determined to be 1, and 15 g/L for this research.
Talcum
Talcum usage in carob pod extract medium was also studied. The pellet radius diameter change did not always have a positive effect on β-mannanase activity. The highest β-mannanase activities with talcum were 469.1 ml, 553.5 U/ml, and 568.7 U/ml for 1, 3, and 5 g/L of talcum, respectively (Fig. 2b). These talcum concentrations were also given the highest production rate results. As described before for aluminum oxide carob pod extract fermentations, there was no significant difference between sugar consumption rates. Addition of 1, 3, and 5 g/L of talcum had just improved the cell growth control and enhanced the mannanase activity. In contrast, addition much more than 5 g/L talcum changed the growth type from pellets to small pellets + filamentous and it was decreased the mannanase activity results.
Both of the microparticles had positive effects with the optimum concentration of microparticle to improve cell morphology and production of β-mannanase, but the β-mannanase activity values were higher with talcum in carob pod extract medium.
Effect on morphology and pellet sizes
Aluminum oxide
The average pellet radius diameter was determined for all aluminum oxide applications in glucose or carob pod extract medium to carry out the fungal morphology. The pellet radius diameter was calculated 1747.8 µm for control fermentation in glucose medium (no addition of aluminum oxide) (Figs. 1a, 3). Higher aluminum oxide concentration in the broth not only changed the fungal morphology and decreased the cell pellet radius, but also increased the number of free pellet cells. For example, the average pellet size was 774.1 µm with 25 g/L of aluminum oxide (Figs. 1a, 3). 25 g/L of aluminum oxide decreased the pellet size by 2.3-fold when compared with control. But the maximum enzyme activity value was 514.0 U/ml with 1 g/L of aluminum oxide and the pellet size was 1605.7 µm.
Addition of aluminum oxide was also a significant importance to control the fermentation system in carob pod extract medium. Because the pellet radius was decrease over than 50 % and it was clearly showed that the aluminum oxide could be used the pellet radius control agent for recombinant A. sojae AsT1 for β-mannanase production. The average pellet radius diameters for aluminum oxide fermentations were ranged from 530.9 to 693.8 µm (Figs. 2a, 4). The highest and the lowest pellet radius diameters were 1482.8 µm for control and 530.9 µm for 10 g/L of aluminum oxide, respectively. Addition of more than 10 g/L of aluminum oxide to fermentation medium was not resulted in decreasing the pellet radius diameters. And also the β-mannanase production was decreased after 15 g/L of aluminum oxide. These were also clearly seen from the Fig. 4 that amount of aluminum oxide improved the number of free cells. At the end, none of the concentrations of aluminum oxide provide the filamentous growth in carob or glucose medium.
Talcum
The changes of pellet size diameter are shown in Fig. 1b for talcum experiments in glucose medium. When comparing the pellet sizes addition of 1 g/L or more talcum was decreased the pellet size much more than the same amount of aluminum oxide (Fig. 1a, b). It was also clearly seen when comparing the microscopic images (Figs. 3, 5). Addition of 1 g/L of talcum decreased the pellet size from 1747.8 µm (control) to 520.9 µm. The lowest pellet size value was calculated to be 392.5 µm for 25 g/L of talcum. The hyphae development was also seen for talcum assays for nearly all concentration within glucose medium. The image analyses were also carried out that the addition more than 10 g/L of talcum changed the filamentous fungi growth type from pellet to pellet/mycelium mixed type (Fig. 5). Then the results clearly showed that the right concentration of the talcum addition improves the fermentation conditions for β-mannanase fermentation with Aspergillus sojae.
Although it was carried out that the pellet radius’s standard error values for talcum fermentations were higher than aluminum oxide fermentations in carob pod extract medium, the lowest pellet radius diameter values were achieved when talc microparticles were used to produce β-mannanase. The pellet radius variety was clearly seen from Figs. 2b, 6. The results indicated that addition more than 1 g/L of talcum always decreased the average pellet radius diameter, and the highest and lowest diameter values were 1321.0 µm for 1 g/L of talcum and 358.3 µm for 25 g/L of talcum respectively (Fig. 2b). Although addition of microparticles decreased the pellet radius, variety of pellet radius was increased, and also the hyphae development was improved for talcum addition more than 10 g/L. These results were indicated that the optimum microparticle concentration had to be determined before the production.
Effect of microparticles in different carbon sources
Sugar consumption and β-mannanase production rates were calculated for all microparticle concentrations in both media. The concentrations of aluminum oxide or talcum were not significant effect on sugar consumption rates for carob pod extract medium (Table 1). The highest sugar consumption rate was 11.9 g/L/day for 25 g/L of talcum in glucose medium. However, the highest production rate was calculated as 57.0 U/ml/day for 1 g/L of aluminum oxide in glucose medium. It was clearly seen that addition of aluminum oxide or talcum affected the fermentation results. However, the optimum concentration of microparticle was different for glucose (1 g/L of aluminum oxide) than the carob pod extract medium (5 g/L of talcum). The highest two mannanase activities were 568.7 U/ml for 5 g/L of talcum in carob pod extract medium and 514.0 U/ml for 1 g/L of aluminum oxide in glucose medium. It was also observed that the higher levels of microparticle concentration resulted in the microorganism growth from pellet to filamentous (Table 1).
Changing microorganism growth type with amount of microparticle concentration could be explained as described by Coban et al. [21] and Kaup et al. [18]. They reported that higher concentrations of microparticle can increase the viscosity of the fermentation broth and it could be resulted in very small fungal growth. This high viscosity caused to decrease production values. Driouch et al. [20] was also reported that free mycelium was formed with increasing the concentration of microparticles (talc or aluminum oxide), however it should be used to more aluminum oxide than talcum for obtaining free mycelium form [19]. Aspergillus ficuum phytase production was also studied by Coban et al. [21] in shake flask fermentation. They carried out that the addition of 15 g/L of aluminum oxide and talcum was decreased (pellet diameter) from 800 μm to 500 and 200 μm, respectively. The phytase activity was also increased. The shake flask lactic acid fermentation by Rhizopus oryzae was showed that 15 g/L aluminum oxide or 10 g/L talcum addition increased the lactic acid concentration from 6.02 to 13.88 and 24.01 g/L, respectively [23]. All of the studies about microparticle reported that addition of microparticle decreased the fungal pellet size. That was also carried out that the right amount of microparticle was improved the production results. Therefore, it can be concluded that the microparticles can be used for fungal fermentation to improve production and control the microbial cell growth in fermentations.
Conclusions
In this study, the effects of microparticles were evaluated on mannanase production. Aluminum oxide was the best agent for glucose medium which resulted in 514.0 U/ml with 1 g/L of aluminum oxide. However, the highest mannanase activity was found as 568.7 U/ml by addition of 5 g/L of talcum in carob extract medium. The pellet size of A. sojae was also decreased under 1000 µm with the addition of 5 g/L and more aluminum oxide addition and any amount of talcum addition. Overall, the addition of right type and amount of microparticle enhanced the mannanase activity, and the hyphae growth.
References
Aehle W (2004) Enzymes in industry. Wiley-VCH Verlag GmbH & Co. KGaA, Weinheim
Rosengren A, Reddy SK, Sjöberg JS, Aurelius O, Logan DT, Kolenova K, Stalbrand H (2014) An Aspergillus nidulans β-mannanase with high transglycosylation capacity revealed through comparative studies within glycosidase family 5. Appl Microbiol Biot 98(24):10091–10104
Van Zyl WH, Rose SH, Trollope K, Görgens JF (2010) Fungal β-mannanases: mannan hydrolysis, heterologous production and biotechnological applications. Process Biochem 45:1203–1213
Lu H, Luo H, Shi P, Huang H, Meng K, Yang P, Yao B (2014) A novel thermophilic endo-β-1,4 mannanase from Aspergillus nidulans XZ3: functional roles of carbohydrate-binding module and Thr/Ser rich linker region. Appl Microbiol Biot 98:2155–2163
Lin SS, Dou WF, Xu HY, Li HZ, Xu ZH, Ma YH (2007) Optimization of medium composition for the production of alkaline β-mannanase by alkaliphilic Bacillus sp. N16-5 using response surface methodology. Appl Microbiol Biot 75(5):1015–1022
Huang JL, Bao LX, Zou HY, Che SG, Wang GX (2012) High-level production of a cold-active β-mannanase from Bacillus subtilis Bs5 and its molecular cloning and expression. Mol Genet Microbiol Virol 27(4):147–153
Feng Y, He Z, Ong SL, Hu J, Zhang Z, Ng WJ (2003) Optimization of agitation, aeration, and temperature conditions for maximum β-mannanase production. Enzyme Microb Tech 32:282–289
Katrolia P, Yan Q, Zhang P, Zhou P, Yang S, Jiang Z (2013) Gene cloning and enzymatic characterization of an alkali-tolerant endo-1,4-β-mannanase from Rhizomucor miehei. J Agr Food Chem 61:394–401
Yin JS, Liang QL, Li DM, Sun ZT (2012) Optimization of production conditions for β-mannanase using apple pomace as raw material in solid-state fermentation. Ann Microbiol 63:101–108
Wang J, Shao Z, Hong Y, Li C, Fu X, Liu Z (2010) A novel β-mannanase from Pantoea agglomerans A021: gene cloning, expression, purification and characterization. World J Microbiol Biotechnol 26:1777–1784
Chen X, Cao Y, Ding Y, Lu W, Li D (2007) Cloning, functional expression and characterization of Aspergillus sulphures β-mannanase in Pichia pastoris. J Biotechnol 128:452–461
Luo H, Wang K, Huang H, Shi P, Yang P, Yao B (2012) Gene cloning, expression, and biochemical characterization of an alkali-tolerant β-mannanase from Humicola insolens Y1. J Ind Microbiol Biot 39:547–555
Wang Y, Shi P, Luo H, Bai Y, Huang H, Yang P, Xiong H, Yao B (2012) Cloning, over-expression and characterization of an alkali-tolerant endo-β-1,4-mannanase from Penicillium freii F63. J Biosci Bioeng 113(6):710–714
Großwindhager C, Sachslehner A, Nidetzky B, Haltrich D (1999) Endo-β-1,4-D-mannanase is efficiently produced by Sclerotium (Athelia) rolfsii under derepressed conditions. J Biotechnol 67(2–3):189–203
Ozturk B, Cekmecelioglu D, Ogel ZB (2010) Optimal conditions for enhanced β-mannanase production by recombinant Aspergillus sojae. J Mol Catal B Enzym 64:135–139
Turhan I, Bialka KL, Demirci A, Karhan M (2010) Ethanol production from carob extract by using Saccharomyces cerevisiae. Bioresour Tech 101:5290–5296
Yatmaz E, Turhan I, Karhan M (2013) Optimization of ethanol production from carob pod extract using immobilized saccharomyces cerevisiae cells in a stirred tank bioreactor. Bioresour Tech 135:365–371
Kaup BA, Ehrich K, Pescheck M, Schrader J (2008) Microparticle-enhanced cultivation of filamentous microorganisms: increased chloroperoxidase formation by Caldariomyces fumago as an example. Biotechnol Bioeng 99(3):491–498
Driouch H, Hänsch R, Wucherpfennig T, Krull R, Wittman C (2012) Improved enzyme production by bio-pellets of Aspergillus niger: targeted morphology engineering using titanate microparticles. Biotechnol Bioeng 105(6):1058–1068
Driouch H, Sommer B, Wittman C (2010) Morphology engineering of Aspergillus niger for improved enzyme production. Biotechnol Bioeng 109(2):462–471
Coban HB, Demirci A, Turhan I (2015) Microparticle-enhanced Aspergillus ficuum phytase production and evaluation of fungal morphology in submerged fermentation. Bioprocess Biosyst Eng 38(6):1075–1080
Coban HB, Demirci A, Turhan I (2015) Enhanced Aspergillus ficuum phytase production in fed-batch and continuous fermentations in the presence of talcum microparticles. Bioprocess Biosyst Eng 38(8):1431–1436
Coban HB, Demirci A (2016) Enhancement and modeling of microparticle-added Rhizopus oryzae lactic acid production. Bioprocess Biosyst Eng 39:323–330
Duruksu G, Ozturk B, Biely P, Bakır U, Ogel ZB (2009) Cloning, expression and characterization of endo-beta-1,4-mannanase from Aspergillus fumigatus in Aspergillus sojae and Pichia pastoris. Biotechnol Progr 25:271–276
Bailey MJ, Biely P, Poutanen K (1992) Interlaboratory testing methods for assay of xylanase activity. J Biotechnol 23:257–270
Miller GL (1959) Use of dinitrosalicylic acid reagent for determination of reducing sugar. Anal Chem 31:426
Acknowledgments
This study was supported by the TUBITAK foundation (Project number: 112 O 167) and Akdeniz University Research Foundation (Project numbers: 2013.12.0102.017 and FDK-2015-681).
Author information
Authors and Affiliations
Corresponding author
Rights and permissions
About this article
Cite this article
Yatmaz, E., Karahalil, E., Germec, M. et al. Controlling filamentous fungi morphology with microparticles to enhanced β-mannanase production. Bioprocess Biosyst Eng 39, 1391–1399 (2016). https://doi.org/10.1007/s00449-016-1615-8
Received:
Accepted:
Published:
Issue Date:
DOI: https://doi.org/10.1007/s00449-016-1615-8